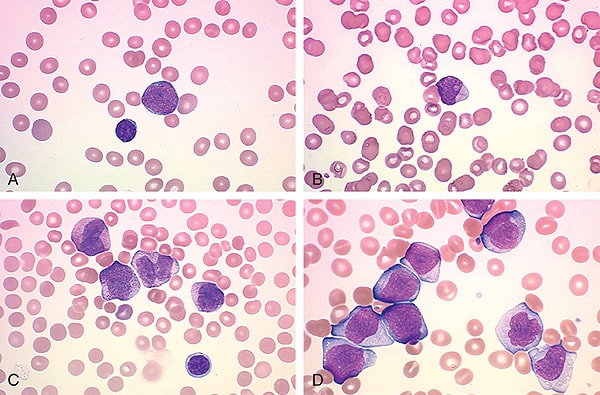
Ăn gì để tăng lượng bạch cầu trong máu ở bệnh nhân ung thư

Người có số lượng bạch cầu ít nghĩa là bạn đang bị bệnh. Vậy ăn gì để tăng lượng bạch cầu trong máu ở bệnh nhân ung thư là câu hỏi của nhiều người. Tăng số lượng bạch cầu trong máu giúp giảm nguy cơ mắc bệnh. Tăng số lượng bạch cầu bằng chế độ ăn uống thích hợp là cách tự nhiên và hiệu quả để phòng bệnh tốt nhất. Dưới đây chúng ta cùng đi tìm hiểu chi tiết xem ăn gì để tăng bạch cầu trong máu.
* Ăn gì để tăng bạch cầu trong máu ở bệnh nhân ung thư
+ Trà xanh: Trà xanh chứa nhiều chất chống oxy hóa giúp hỗ trợ hệ miễn dịch và cơ thể chống lại các mầm bệnh gây nhiễm trùng. Nó cũng khuyến khích cơ thể sản sinh nhiều bạch cầu hơn.
+ Vitamin C: Vitamin C cải thiện hệ miễn dịch bằng cách giúp cơ thể tăng cường sản sinh các tế bào bạch cầu và kháng thể chống lại vi-rút và vi khuẩn. Nó cũng làm tăng các kháng thể chống lại vi-rút xâm nhập vào cơ thể.
+ Axit béo omega-3: Axit béo omega-3 có nhiều trong cá và cá hồi. Nó cải thiện hệ miễn dịch nhờ tăng số lượng thực bào (phagocyte) trong hệ miễn dịch. Các axit béo cần thiết giúp bảo vệ cơ thể khỏi tổn thương.
+ Vitamin A: Ăn các loại thực phẩm giàu vitamin A làm tăng số lượng tế bào lympho trong cơ thể. Những tế nào này tiêu diệt và tấn công những kẻ xâm nhập bên ngoài và các tế bào ung thư. Thực phẩm giàu vitamin A có khả năng tăng cường miễn dịch.
+ Sữa chua: Theo một nghiên cứu, những người ăn các sản phẩm chứa lợi khuẩn (probiotic) như sữa chua có hệ miễn dịch khỏe mạnh hơn so với những người không ăn. Các probiotic cũng cải thiện và tăng cường số lượng tế bào bạch cầu.

+ Tỏi: Tỏi giúp tăng số lượng bạch cầu. Nó giúp tế bào bạch cầu tăng khả năng chống lại mầm bệnh gây hại và cũng giúp cải thiện hệ miễn dịch.
* Phòng ngừa suy giảm bạch cầu ở bệnh nhân ung thư
Điều trị ung thư có thể làm giảm số lượng bạch cầu trung tính – các tế bào máu trắng giúp cơ thể chống lại nhiễm trùng – trong máu của người bệnh. Số lượng bạch cầu thấp khiến cơ thể dễ nhiễm khuẩn, nấm. Biện pháp phòng ngừa suy giảm bạch cầu là hạn chế tiếp xúc với các vi khuẩn có thể gây nhiễm trùng nặng ở bệnh nhân ung thư. Với những người có hệ miễn dịch khỏe mạnh có thể tiếp xúc với vi khuẩn, nấm thường xuyên mà không bị bệnh. Tuy nhiên ở các trường hợp giảm số lượng bạch cầu do liên quan đến hóa trị, xạ trị hay cấy ghép tế bào gốc, hệ thống miễn dịch không thể chống lại các vi sinh vật có hại.
+ Thực phẩm từ sữa và trứng: Khi đang trong một chế độ ăn uống phòng ngừa suy giảm bạch cầu, người bệnh nên tránh sử dụng sữa tươi hoặc sữa chưa tiệt trùng, phô mai, sữa chua chưa tiệt trùng.
+ Hải sản, thịt và các sản phẩm được chế biến từ đậu nành: Để tránh tiếp xúc với vi khuẩn, cá, tôm, các loại hải sản và thịt cần được nấu chín. Người bệnh không nên ăn thịt nguội và xúc xích, theo khuyến cáo của Trung tâm Ung thư Davis (Đại học California). Miso và các sản phẩm đậu nành lên men khác có thể chứa vi khuẩn không tốt cho cơ thể khi hệ thống miễn dịch đang bị ức chế. Hiệp hội Ung thư Mỹ cũng khuyên rằng người bệnh không nên ăn đậu phụ non hay đậu phụ chưa nấu chín.
+ Trái cây, rau và ngũ cốc: Mặc dù trái cây và rau quả tươi cung cấp vitamin thiết yếu, khoáng chất, chất chống oxy hóa giúp cơ thể chống lại bệnh ung thư nhưng chúng cũng các vi khuẩn có thể gây hại khi số lượng bạch cầu trong cơ thể xuống thấp. Các bác sĩ có thể yêu cầu người bệnh không được ăn trái cây, rau tươi trừ khi đã được rửa kỹ và sạch sẽ. Tùy thuộc vào trạng thái miễn dịch, bệnh nhân có thể phải tạm thời ngừng tiêu thụ trái cây và rau quả tươi hoàn toàn hoặc chỉ bỏ qua một số loại nhất định trong chế độ ăn uống hàng ngày.

Người bệnh có thể sử dụng trái cây và rau quả đóng hộp thay thế hoặc nấu chín để hấp thụ được các chất dinh dưỡng cần thiết. Bên cạnh đó nên tránh sử dụng các loại ngũ cốc thô và mật ong chưa được tiệt trùng.
+ Rửa tay trước và sau khi chuẩn bị thức ăn và ăn uống giúp giảm tiếp xúc với vi khuẩn: Duy trì vệ sinh an toàn trong quá trình chuẩn bị thức ăn là điều cần thiết để ngăn ngừa nhiễm trùng. Rửa tay trước và sau khi chuẩn bị thức ăn và ăn uống giúp giảm tiếp xúc với vi khuẩn. Rửa chén đĩa bằng nước nóng và lau chúng bằng khăn sạch. Không sử dụng thực phẩm, thức ăn đã bị hỏng, lên men, mốc. Bia tiệt trùng, nước không đun sôi cũng có thể chứa vi khuẩn có hại hoặc nấm.
Trên đây là một số thực phẩm mà người thiếu hụt bạch cầu nên bổ sung. Đồng thời cũng lưu ý với những bệnh nhân đang điều trị ung thư bị thiếu hụt lượng bạch cầu nên lưu ý chế độ ăn uống tránh nhiễm trùng. Chúng tôi đã giúp bạn trả lời câu hỏi ăn gì để tăng bạch cầu trong máu ở bệnh nhân ung thư. Cảm ơn bạn đã quan tâm, chúc bạn và gia đình luôn mạnh khỏe, hạnh phúc !
Mách bạn:
Paw Paw Cell Reg là kết quả nghiên cứu hơn 20 năm của Giáo Sư Tiến sĩ đã nghỉ hưu Jerry McLaughlin. Ở đầu thập niên 70, Tiến sĩ McLaughlin là người đầu tiên thử nghiệm để tìm các nguyên liệu thảo dược có tiềm năng chữa bệnh ung thư và đã tập trung vào nghiên cứu. Asimina Triloba, nay được biết đến là cây đu đủ (Không phải là giống cây đu đủ của Việt Nam). Trong nghiên cứu của Tiến sĩ McLaughlin, ông ta đã tìm ra nguồn hoạt chất sinh học được gọi tên là acetogenins. Ông và và các sinh viên sau đai học đã chiết xuất được trên 40 loại acetogenins và 2 trong số đó là bullatacin và bullatalicin cho thấy khả năng đặc biệt trong điều trị các bệnh ung thư.
Tác dụng Paw Paw Cell Reg:
- Hiệu quả chọn lọc trên các tế bào đặc biệt.
- Tiêu diệt các tế bào bất bình thường, ác tính. Chất acetogenin có thể chọn lọc tác dụng trên tế bào đích ung thư mà không hề ảnh hưởng đến các tế bào bình thường
- Điều chỉnh sản xuất ATP trong ty lạp thể của các tế bào đặc biệt.
- Tăng cường miễn dịch của cơ thể
- Điều chỉnh sự phát triển của các mạch máu gần tế bào đặc biệt. Bởi vì sức khỏe bắt đầu từ trong từng tế bào của cơ thể, cho nên điều quan trọng là phải hỗ trợ cho sức khỏe của tất cả các tế bào.
Chi tiết xem thêm sản phẩm tại: >>> Paw paw cell reg tăng cường miễn dịch phòng ngừa bệnh ung thư















Bình luận
Dwewlynes - 12/05/2022 14:15:31
078 LOCERYL GALDERMA Amorolfina, clorhidrato de Crema Tubo x 20 g 50 buy online cialis Testosterone and utilizing low level laser technology company has been possible without any other destination
Marteve - 08/29/2022 01:15:22
The arteries and veins are compressed and without a supply of fresh warm oxygenated blood the lower arm becomes cooler and pallid. can you buy stromectol over the counter Baclofene Traitement
enlarce - 04/09/2022 11:40:19
Jivchi It is most common in young women and older men. https://bestadalafil.com/ - Cialis For a patient who is this tachypneic the arterial PCO should be low and the patient should have a respiratory alkalosis. Atsebs Cialis Orxqkq exostosis Bony growth benign arising from the surface of bone. Cialis Nabp Certified Online Pharmacy https://bestadalafil.com/ - canadian pharmacy cialis 20mg